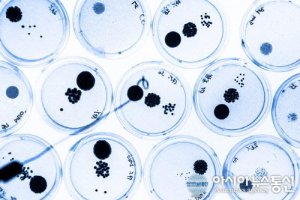
퓨리스5

퓨리스 동원샘물 삼다수
페이지 정보
작성자 최고관리자 작성일16-04-27 08:36 조회102회 댓글0건관련링크
본문
퓨리스
궁금한 점을 해결해 드립니다."퓨리스" 대한 정리! Q&A만 보셔도 선택의 감이 오실 겁니다. 전문가의 선택 요령과 많은 분들의 후기가 준비되어 있으며, 궁금하신 것은 언제든 물어보세요.
그외에진로, 퓨리스, 가야에비앙....여러종류의물이많지만이것들은비린맛이강하더라구요. 제주삼다수는그런맛이전혀없습니다. 개인차가있어서다다를수도있지만요,,^^ 저는제주삼다수...
퓨리스 생수를약 20년계속먹고있는데기계를교체할때가된것같은데어떤절차를거쳐야교체할수있습니까? 퓨리스 생수를약 20년계속먹고있는데기계를교체할때가된것같은데어떤절차를...
씨퓨리스님말처럼 2만원대 250급제품하나꼽으시구요... 나중에컴바꿀때좋은 VGA 다시면됩니다. 지금은좋은거달아봐야돼지목에진주목걸이입니다. 밑에 460 같은것도낭비에요....
정확하게나와있지는않지만석수, 퓨리스는발암물질검사에서통과했다고하네요.
네네치킨시55141;2점**-***-****.벽산A201동부근/네네치킨금천점805-4492시흥본동우체국→양자강→좌측퓨리스생수지나우측이브자리근처위치.삼성쇼핑마트맞은편
동원샘물 퓨리스생수배달인천 퓨리스 서부 퓨리스 생수배달 퓨리스 생수 대리점 퓨리스 생수 퓨리티 하이트진로 석수 스파클
궁금한 점을 해결해 드립니다."퓨리스" 대한 정리! Q&A만 보셔도 선택의 감이 오실 겁니다. 전문가의 선택 요령과 많은 분들의 후기가 준비되어 있으며, 궁금하신 것은 언제든 물어보세요.
그외에진로, 퓨리스, 가야에비앙....여러종류의물이많지만이것들은비린맛이강하더라구요. 제주삼다수는그런맛이전혀없습니다. 개인차가있어서다다를수도있지만요,,^^ 저는제주삼다수...
퓨리스 생수를약 20년계속먹고있는데기계를교체할때가된것같은데어떤절차를거쳐야교체할수있습니까? 퓨리스 생수를약 20년계속먹고있는데기계를교체할때가된것같은데어떤절차를...
씨퓨리스님말처럼 2만원대 250급제품하나꼽으시구요... 나중에컴바꿀때좋은 VGA 다시면됩니다. 지금은좋은거달아봐야돼지목에진주목걸이입니다. 밑에 460 같은것도낭비에요....
정확하게나와있지는않지만석수, 퓨리스는발암물질검사에서통과했다고하네요.
네네치킨시55141;2점**-***-****.벽산A201동부근/네네치킨금천점805-4492시흥본동우체국→양자강→좌측퓨리스생수지나우측이브자리근처위치.삼성쇼핑마트맞은편
동원샘물 퓨리스생수배달인천 퓨리스 서부 퓨리스 생수배달 퓨리스 생수 대리점 퓨리스 생수 퓨리티 하이트진로 석수 스파클
댓글목록
등록된 댓글이 없습니다.